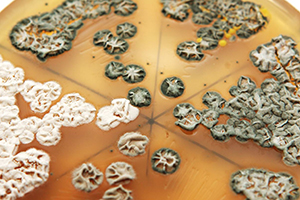
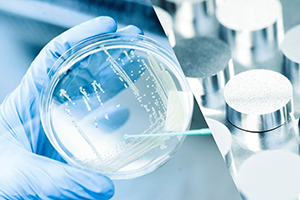

Sundhedsteknologi
Disciplinerne medicinsk udstyr og teknologier til sundhedsområdet kræver specialisering og tværfagligt samarbejde. Teknologisk Institut har ekspertisen og faciliteterne til at hjælpe din virksomhed med rådgivning og udvikling og råder desuden over alle fornødne laboratoriefaciliteter.
Teknologisk Instituts laboratorier og kompetencer dækker bl.a. følgende områder - klik på links under de enkelte emner for at læse mere:
Â
 Tæthed og hyldelevetid
Tæthed og hyldelevetid
Sterilisation kan påvirke såvel device som den emballage, der sikrer sterilitet, og Teknologisk Institut assisterer derfor virksomheder med at dokumentere, at virksomhedens produkter kan anvendes sikkert af slutbrugeren. Forud for tæthedsundersøgelserne udfordres produkterne ved eksponering for accelereret ældning og forskellige former for belastning, der simulerer transport.
 3D-print
3D-print
Center for Industriel 3D-print har solid erfaring med 3D-print og hjælper danske virksomheder med en lang række ydelser - fra produktudvikling og 3D-print-produktion til kvalitetskontrol. Teknologisk Institut printer i en lang række plast- og metalmaterialer og har fremstillet emner til en række kunder i medicoindustrien.
- 3D-print produktion
- Case: Hegenberger Speculum accelererer udviklingsforløb med 3D-print
- Case: 3D-printede nyloncovers i produkterne
 Installation og kalibrering af medicinsk udstyr
Installation og kalibrering af medicinsk udstyr
Teknologisk Instituts kalibreringslaboratorier sikrer, at medicinalindustrien har sporbar kalibrering af deres måletekniske udstyr på højeste niveau - fx inden for temperatur, flowmåling, tryk og fugt. Teknologisk Institut yder rådgiver om måleteknik, valideringsmetoder og usikkerhedsberegninger for udstyr og samlede processer, og i forsknings- og udviklingsprojekter udvikler Instituttet sammen med kunderne nye måletekniske metoder og sikrer viden om ydeevne for såvel produkt som produktion.

Test af medicinsk udstyr og in-vitro diagnostiske produkter
Vi tilbyder kemiske analyser af medicinsk udstyr i henhold fx til ISO 10993-18 samt relevant USP'er til biologisk vurdering af det medicinske udstyr og til at dokumentere, at der ikke er biologiske risici forbundet med anvendelsen af udstyret.Vi tilbyder også test af stabilitet og funktionalitet af IVD-reagenser men også af lægemidler som fx benyttes i kombinationsprodukter (drug/device-produkter)
- Kemisk karakterisering af medicinsk udstyrâ
- Test og Udvikling af In Vitro Diagnostik (IVD) - Stabilitet af IVD-produkter
 Plastanalyse og processering
Plastanalyse og processering
Vi arbejder med fokus på rette materialevalg samt akkrediterede standardtest af materialer (ISO, ASTM og DIN). Vi tilbyder hurtig sprøjtestøbning af prototyper, samt sprøjtestøbning af freeform geometrier ved brug af 3D-printede opløselige støbeforme.Vi forsyner også producenter med den nyeste viden om materialernes kemiske, toksiske og biologiske egenskaber i forbindelse med produktudvikling eller ved godkendelse af medicotekniske produkter.
 Transportprøvning af emballage
Transportprøvning af emballage
Vi kan hjælpe med transportprøvning af emballage til medicin og medicinsk udstyr. Når varer transporteres, udsættes de nemlig for mekaniske og klimatiske påvirkninger, såsom stød, rystelser, stablingsbelastning, temperatur og fugtighed. Prøvning i laboratoriet med simulerede transportpåvirkninger er en sikker metode til at måle emballagens funktionsegenskaber â og de påvirkninger, der anvendes i laboratoriet, er reproducerbare. Hele vores testcenter er DANAK-akkrediteret til udførelse af transporttest
Mikrobiologi, biofilm og hygiejne
Mikrobiologi, biofilm og hygiejne
Vi tilbyder molekylærbiologiske specialistydelser til bl.a. udvikling af in vitro diagnostik, sensorer og vacciner.
- Proteser: Reduktion af infektioner og smerter
- UV-induceret biofilm forebyggelseâ
- Hygiejne-monitorering på sygehuse
Tribologi
Tribologi
Vi arbejder med overfladebelægninger af medicinsk udstyr og produkter, bl.a. lavfriktionsbelægninger til dentale skruer, Sr-afgivende overflader til accelereret knogledannelse, porøs TiN til effektiv nervestimulering samt CrN-SS til højtydende sprøjtestøbeforme.
- Strontium-holdige (Sr) belægninger til accelereret knogledannelseâ
- Belægning af elektrode til nervestimuleringâ
Â
Operationsmasker og mundbind
Operationsmasker, også kaldet mundbind, skal sikre trygheden for patienter og sundhedspersonale. Der findes forskellige typer til forskellige formål - modellerne hedder Type I, Type II og Type IIR. Maskerne ser umiddelbart simple ud, men kravene til deres funktionsegenskaber er relativt skrappe. For at de kan blive godkendt, skal de opfylde EN-standarden 14683. Vi tester som udgangspunkt ikke brugervenlighed af operationsmaskerne.
Vi kan hjælpe med at teste:
- Filtreringsevne ifølge EN14683
- Åndbarhed
- Beskyttelse med væskesprøjt
- âBioburden af forskellige emner
Robotteknologi
Robotteknologi kan anvendes til at automatisere opgaver på fx hospitaler og i medico-industrien. Det kan fx være ved at screene og sortere prøver, til desinfektion og rengøring, til transport af materiale samt til aflastning af personale ved tunge og belastende arbejdspositioner. Vi hjælper med kortlægning af behov, afsøgning af mulige eksisterende løsninger samt tilpasning og udvikling af nye robot- og automationsløsninger.
Printet elektronik
Vi arbejder med sundhedsmonitorering ved hjælp af vaskbare og strækbare bærbare sensorer integreret direkte på tekstiler og fleksible materialer. Fleksible elektroder til EKG, EMG og EEG sikrer præcis og mobil monitorering uden at hæmme bevægelsesfrihed. Intelligente beklædningsgenstande med indbyggede sensorer åbner for avanceret og personaliseret sundhedspleje tilpasset den enkelte. Vores teknologier muliggør "indlagt i eget hjem"-koncepter, hvor patienter kan modtage pleje i trygge omgivelser.Â
Sundhedsdata
Vi arbejder med sundhedsdata i flere tværdisciplinære konsortier, herunder både registerdata, data fra kommuner og i særdeleshed patientrapporterede oplysninger (fx smerte, størrelse på sår, trivsel og humør) og borgerskabte data (fx fysisk aktivitet og puls) opsamlet fra henholdsvis apps, smartphones og wearables. Borgeren/patienten er i centrum, og der udvikles og testes produkter i tæt samarbejde med både borgere, pårørende og sundhedsfaglige personer.
- CoronaViden
- HealthD360 â sundhedsdata der skaber værdi for borgerne
- Patienter skal selv være med til at dokumentere effekten af deres behandling
- PhaseV (Fase 5) â et tværsektorielt innovationsprojekt baseret på borgerskabte data

Mikroanalyse og imaging
I Mikroanalyse og Imaging hjælper vi pharma og medico virksomheder med at forstå og beskytte deres produkter. Vi er DANAK-akkrediteret til at undersøge og præcist isolere meget små partikler, som f.eks. findes i produktionen.
Ved at bruge billedbehandlingsteknikker hjælper vi dig med at undersøge dit produkts interne struktur ned til mindste detalje uden at skulle skære det i stykker. Vores coating produktion giver bedre ydeevne og længere levetid til medico produkter og komponenter, der er udsat for vand og olie.
- Identifikation af fremmed materiale - Akkrediteret undersøgelse
- Ikke-destruktiv kvalitetskontrol - MikroCT
- Beskyt dit produkt med nano-coatingâ
 Renluft-teknologier - validering, udvikling og rådgivning
Renluft-teknologier - validering, udvikling og rådgivning
I Luft- og Sensorteknologi har vi mange års erfaring med at validere og udvikle renseteknologier til forbedring af indeklimaet og reduktion af patogene mikroorganismer i luften og på overflader. Disse teknologier anvendes bredt indenfor plejehjem, sygehuse, og i det private rum. Vi rådgiver om brugen af luftrensere i det offentlige rum, og tester, analyserer og måler på indeklimaet ved brug af state-of-the-art udstyr eller low-cost sensorer. Vi har bl.a. samarbejdet med Statens Serum Institut om tekniske løsninger til at nedbringe smittespredning i skoleklasser og hjulpet Aarhus Kommune med at mindske lugtgener i vaskerum på plejehjem.
- Sådan fik Aarhus kommune mindsket lugtgener i ældreplejen
- Mobile luftrensere - Hvor godt virker de
- Udvikling og test af luftrensere og filterteknologier
- Luftrensning - virus og bakterier
 Digital sundhed og mental trivsel
Digital sundhed og mental trivsel
Digitale sundhedsteknologier og AI skaber i disse år helt nye muligheder for at udvikle bedre og mere effektive behandlingsmetoder til gavn for patienter, private virksomheder og sundhedsvæsenet. Digitalisering og brugen af AI er desuden et helt centralt element i omstillingen til et mere borgernært, fleksibelt og effektivt sundhedsvæsen, herunder også i forhold til skabe et mere tolerant og inkluderende samfund for udsatte og sårbare borgere. På Teknologisk Institut brænder vi for at udvikle nye innovative og digitale sundhedsløsninger, som gør en forskel for patienter og pårørende og inkluderer brugerne og medarbejderne i udviklingen og implementeringen.
 Teknologivurdering og forretningsudvikling
Teknologivurdering og forretningsudvikling
"Teknologi er nemt - implementering er svært". Det er et billede, vi ofte ser på Teknologisk Institut, hvor vi i mange år har hjulpet virksomheder og offentlige myndigheder med at udvikle og implementere løsninger, der skal bruges i hverdagen og skabe værdi for borgere, brugere eller kunder. På Teknologisk Institut er vi eksperter i at foretage screeninger og vurderinger af nye sundhedsteknologiers teknologiske og kommercielle potentialer, herunder at lave uafhængige evalueringer af nye teknologier og understøtte den konkrete implementering.
Â